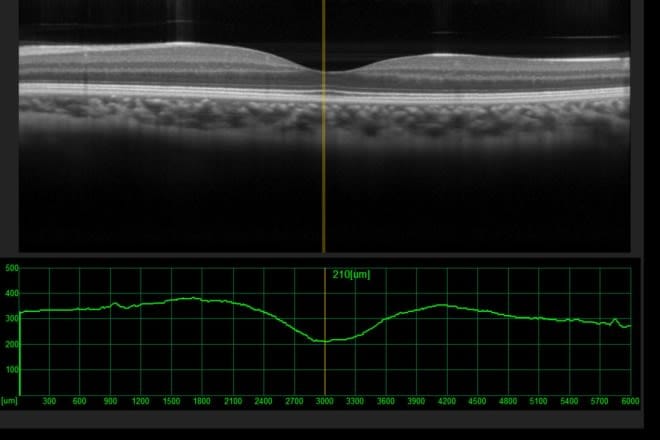

What is central serous chorioretinopathy?
Central serous chorioretinopathy (CSCR) is when fluid leaks behind the retina and causes swelling. It's a common type of retinopathy, the medical word for a problem with the retina.
The retina is a layer of cells along the inner back wall of your eye. The cells send light signals to your brain so you can see.
Chorioretinopathy (kor-ee-oh-reh-tuh-NAH-puh-thee) means the retina problem is related to your choroid. This is the thin layer of blood vessels underneath your retina.
This eye disorder goes by different names, but they all mean the same thing:
Central serous chorioretinopathy
Central serous retinopathy
Central serous choroidopathy
The medical abbreviation can be CSCR, CSR or CSC.
Symptoms, causes and risk factors
What are the signs and symptoms of central serous retinopathy?
Possible symptoms include:
Blurry vision in the center of your view
A blind spot in the center of your vision
Straight lines and objects look wavy or distorted
Things look smaller or further away than they should
White objects seem dull or brownish in color
These symptoms can happen in one eye (more common) or both. People over age 50 are more likely to have symptoms in both eyes.
Some people don't have any symptoms. An eye doctor can still see the signs of CSCR during an eye exam, even if your vision looks normal.
Around 15% of people still have symptoms after six months. This is called chronic central serous chorioretinopathy.
What causes central serous retinopathy?
Researchers don't know exactly what causes central serous chorioretinopathy.
Some people are more likely to get CSCR than others. This information could help researchers find answers in the future.
Who is at risk for central serous retinopathy?
Males are about six times more likely to have central serous chorioretinopathy than females. The eye condition is more common in people in their 40s, but it can happen at any age.
Studies show that roughly 30-50% of people who have had CSCR have it again in the future.
Other risk factors for central serous chorioretinopathy include:
Stress
Type A personality (very competitive and motivated by goals or achievements)
Steroid medication use
Sleep apnea
High blood pressure that isn't treated
H. pylori infection (a common bacterial infection in the stomach)
Gastroesophageal reflux disease (GERD)
Certain autoimmune diseases, like lupus
Relation to someone with CSCR
READ MORE: What are the other types of retinopathy?
Testing and diagnosis

Optical coherence tomography (OCT)
A medical eye doctor (ophthalmologist) will perform certain tests during your exam. These procedures can tell them whether you have CSCR or a similar eye disorder.
The doctor will use eye drops to dilate (widen) your pupils beforehand. It's painless, but it will make your vision blurry and sensitive to light for a few hours.
Afterward, they'll likely use fluorescein angiography (FA) or optical coherence tomography (OCT).
Fluorescein angiography (FA)
Your eye doctor injects a dye called fluorescein into your arm. It eventually reaches your eye and makes "problem areas" more visible to the doctor.
Optical coherence tomography (OCT)
The ophthalmologist uses an OCT machine to scan the inside of your eye for a 3D view of your retina. It helps them see things that shouldn't be there, like the swelling caused by CSCR.
An OCT exam takes 5 to 10 minutes and doesn't hurt.
Central serous retinopathy treatment
Most people don't need treatment for central serous chorioretinopathy. The symptoms usually go away within one to two months.
Your ophthalmologist may need to monitor your eyes during this time. They may also recommend taking steps to speed up your recovery:
Reduce stress as much as possible.
Safely stop using steroids or any other medicine that could make your condition worse. If it isn't possible to stop using a drug, your doctor may suggest lowering the dosage.
Treat other conditions like sleep apnea or high blood pressure if you aren't already.
Your eye doctor will work together with your other providers if another health problem or medication is involved.
You will probably need eye treatment if:
You have severe vision symptoms
Your symptoms don't improve on their own
The goal of treatment is to heal your eye so vision problems don't become permanent.
Your eye doctor may recommend:
Laser photocoagulation
During laser photocoagulation, the doctor uses lasers to make microscopic burns on your retina. This helps get rid of the fluid underneath.
The procedure isn't painful, and you'll be awake the entire time.
Photodynamic therapy (PDT)
Ophthalmologists use medicine and lasers during photodynamic therapy.
First, they inject a light-activated drug called verteporfin into your arm. Once it reaches your eye, the doctor targets the leaky blood vessels with a laser. The laser combines with the drug and seals off the leaks.
Medications
Studies show that certain oral medications (taken by mouth) could help some patients. These include types of anti-corticosteroids and adrenergic blockers.
Treating H. pylori-related stomach ulcers may also help some people with chronic CSCR.
Some studies suggest certain NSAIDs (non-steroidal anti-inflammatory drugs) may speed up recovery. These drugs could be widely used through pills or eye drops one day, but more research is needed.
Your doctor will decide if any of these medications could help you recover.
Prevention
There isn't a proven way to prevent central serous chorioretinopathy.
Scientists haven't found clear proof that reducing stress prevents CSCR. But practicing stress reduction techniques could help you avoid other stress-related vision problems.
Outlook
Having central serous chorioretinopathy can be frightening. Fortunately, most people get their full vision back within a couple months.
Less often, this eye disease can cause long-term eyesight changes. In these cases treatment could help you recover your vision.
Schedule an eye exam any time you notice changes in your eyesight. Your eye doctor will check for CSCR and other eye problems that cause similar symptoms.

